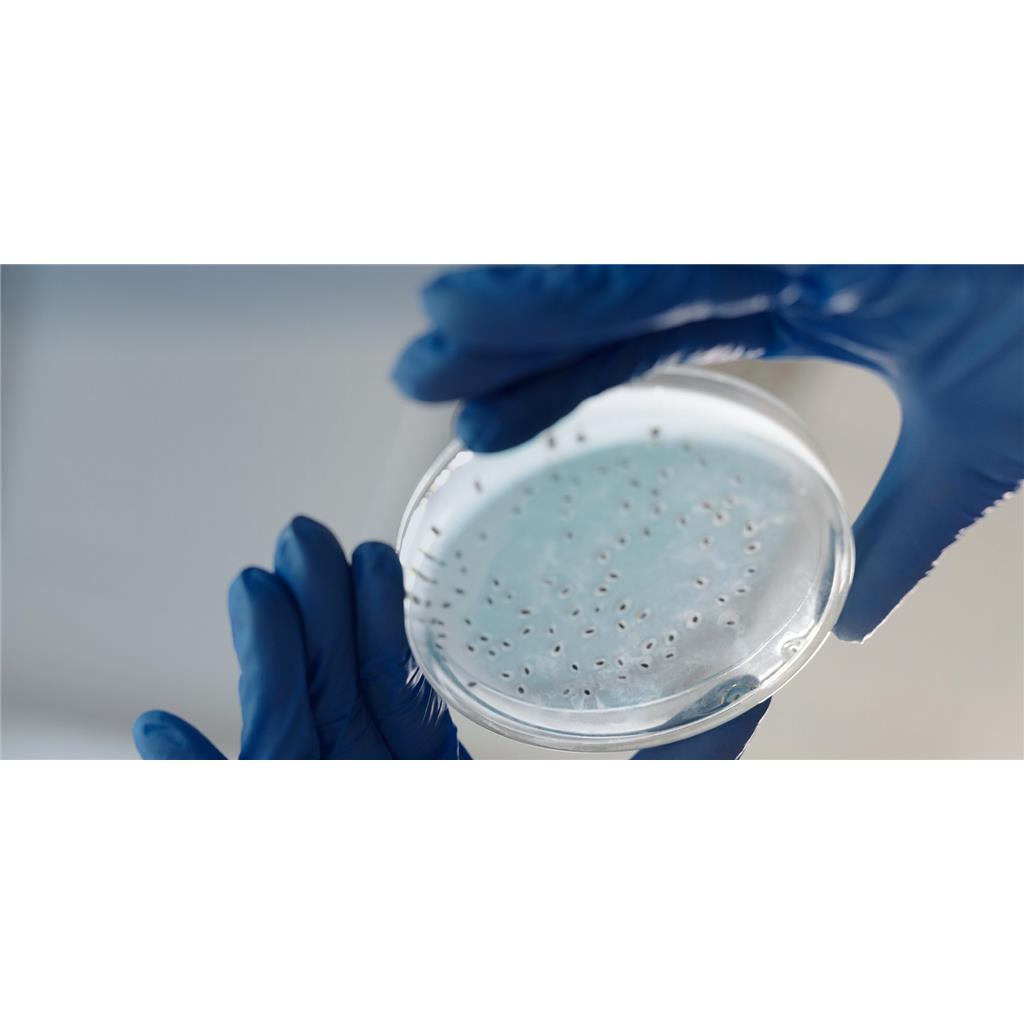
大规模发酵技术服务

大规模发酵技术服务
询价
1项目
起订
天津 更新日期:2026-03-23
产品详情:
- 中文名称:
- 大规模发酵技术服务
- 产品类别:
- 大规模发酵技术
公司简介
卡梅德生物科技(天津)有限公司作为国家级高新技术企业,专注于为全球科学家和研究机构提供天然蛋白提取与发酵、重组蛋白定制表达服务,单、多克隆抗体开发,噬菌体文库构建与筛选服务;同时,基于我公司成熟的五大核心技术服务平台,成功研发了众多用于科学研究的重组蛋白、抗体、抗体药物靶点蛋白、工业酶、诊断原料等相关试剂。
| 成立日期 | (12年) |
| 注册资本 | 100万 |
| 员工人数 | 10-50人 |
| 年营业额 | ¥ 100万以内 |
| 经营模式 | 试剂,定制,服务 |
| 主营行业 | 生物化工,抗体,生物技术服务,第三方检测技术服务,整体实验外包服务 |
大规模发酵技术服务相关厂家报价
-

- 灭草烟-咪唑烟酸81334-34-1标准品工艺技术服务
- 湖北威德利化学试剂有限公司 VIP
- 2026-04-06
- ¥700
-

- 生物发酵罐二手微生物发酵罐 不锈钢菌种发酵装置 大小型种子罐
- 梁山浩顺机械设备有限公司
- 2026-04-05
- 询价
-

- 流式细胞检测技术服务
- 北京博奥森生物技术有限公司
- 2026-04-05
- 询价